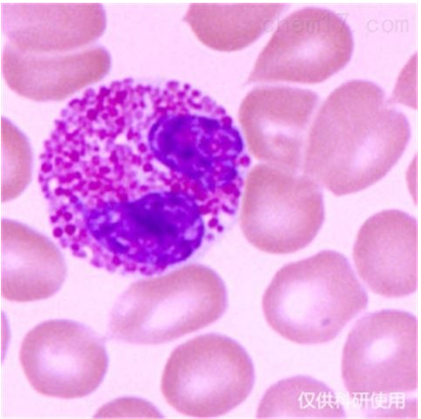

技術文獻
相關資訊
技術文獻
Neuro-2a/N2a(小鼠腦神經瘤細胞)細胞培養的優點:
1.研究的對象是活細胞
在實驗過程中,根據要求可始終保持細胞活力,并可長時間監控、檢測甚至定量評估一部分活細胞的情況,包括活細胞的形態、結構、生命活動等。
2.研究條件可以人為控制
pH、溫度、氧氣、二氧化碳、張力等物理化學的條件,可以根據實際需要進行人為的控制,同時,可以施加化學、物理、生物等因素作為條件而進行實驗觀察,這些因素同樣可以處于嚴格控制之下。
3.研究的樣本可以達到比較均一性

通過細胞培養一定代數后,所得到的細胞系則可以達到均一性而屬于同一類型的細胞,需要時,可采用克隆化等方法使細胞達到純化。
4.研究內容便于觀察、檢測和記錄
采用各種研究技術:如倒置生物顯微鏡、熒光顯微鏡、電子顯微鏡、流式細胞術、激光共焦顯微鏡、免疫組織化學、原位雜交、同位素標記等各種儀器設備
記錄方式可采用攝影照片、縮時電影、電視等多種手段。
5.研究的范圍比較廣泛
應用的學科領域較為寬廣,如細胞學、免疫學、腫瘤學、生物化學、遺傳學、分子生物學等;
適用的對象范圍廣,從低等動物到高等動物,一種動物的不同年齡階段以及不同組織,都可進行有針對性的研究。
6.研究的費用相對較經濟
1.研究的對象是活細胞
在實驗過程中,根據要求可始終保持細胞活力,并可長時間監控、檢測甚至定量評估一部分活細胞的情況,包括活細胞的形態、結構、生命活動等。
2.研究條件可以人為控制
pH、溫度、氧氣、二氧化碳、張力等物理化學的條件,可以根據實際需要進行人為的控制,同時,可以施加化學、物理、生物等因素作為條件而進行實驗觀察,這些因素同樣可以處于嚴格控制之下。
3.研究的樣本可以達到比較均一性
通過細胞培養一定代數后,所得到的細胞系則可以達到均一性而屬于同一類型的細胞,需要時,可采用克隆化等方法使細胞達到純化。
4.研究內容便于觀察、檢測和記錄
采用各種研究技術:如倒置生物顯微鏡、熒光顯微鏡、電子顯微鏡、流式細胞術、激光共焦顯微鏡、免疫組織化學、原位雜交、同位素標記等各種儀器設備
記錄方式可采用攝影照片、縮時電影、電視等多種手段。
5.研究的范圍比較廣泛
應用的學科領域較為寬廣,如細胞學、免疫學、腫瘤學、生物化學、遺傳學、分子生物學等;
適用的對象范圍廣,從低等動物到高等動物,一種動物的不同年齡階段以及不同組織,都可進行有針對性的研究。
6.研究的費用相對較經濟
